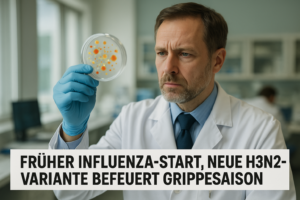

📰 Beschluss im Kreistag Der Kreistag des Landkreises Görlitz hat am Mittwoch einem Antrag zugestimmt, der auf allen kreiseigenen Flächen und bei kreisorganisierten Veranstaltungen Werbung für Militärdienst und Rüstungsprodukte ausschließt. In seiner Funktion als Kreistagsmitglied votierte AfD-Bundes- und Fraktionschef Tino Chrupalla dafür. Der Beschluss löste unmittelbar juristische und politische Debatten über Zuständigkeiten und Signalwirkung aus.
📚 Hintergrund und Vorgeschichte Eingebracht wurde der Antrag vom Bündnis Sahra Wagenknecht unter dem Titel „Landkreis Görlitz – Landkreis des Friedens“. Bereits im Oktober fasste der Kreistag einen inhaltlich ähnlichen Beschluss, gegen den Landrat Stephan Meyer von der CDU Widerspruch einlegte; deshalb kam es zur erneuten Abstimmung. Meyer kündigte auch nach dem neuen Votum abermals Widerspruch an, da Nachwuchswerbung und Verteidigung Bundesangelegenheiten seien; über das weitere Vorgehen hat die Rechtsaufsicht zu entscheiden.
🧩 Umfang des Werbeverzichts Der beschlossene Verzicht betrifft sämtliche Gebäude, Einrichtungen, Unternehmen und Fahrzeuge des Landkreises sowie Präsentationsflächen im Verantwortungsbereich der Verwaltung. Gleiches gilt für Veranstaltungen mit Beteiligung kreiseigener Stellen. Damit wird die Nutzung öffentlicher Räume des Landkreises für entsprechende Werbemaßnahmen systematisch ausgeschlossen.
🗳️ Mehrheiten und Begründungen Die Mehrheit kam mit den Stimmen der AfD-Fraktion und eines Mitglieds der Linken zustande. Tino Chrupalla begründete seine Zustimmung sinngemäß damit, ernst gemeinten Friedensanträgen solle man zustimmen und die Bundeswehr solle besser in ihre Fähigkeiten zur Landes- und Bündnisverteidigung investieren als in Werbeplakate an Rathäusern, Bushaltestellen oder Schulen. Auch die Görlitzer AfD-Fraktion stellte Deeskalation und Diplomatie als Leitlinien heraus.
⚖️ Rechtliche Einordnung Der Beschluss ist politisch hoch aufgeladen und rechtlich angreifbar. Werberegeln für die Bundeswehr werden im Kern auf Bundesebene gesetzt; ein kommunaler Werbeverzicht hat daher vor allem symbolischen Charakter. Landrat Stephan Meyer verweist auf die Bundeszuständigkeit, und die kommunale Rechtsaufsicht muss über das weitere Vorgehen entscheiden.
📌 Signalwirkung und Ausblick Konservative Realpolitik wird sich daran messen lassen müssen, ob sie die Streitkräfte stärkt, ohne vor Ort in Kompetenzstreitigkeiten zu verfallen. Bis zur Klärung der Rechtslage bleibt der Görlitzer Beschluss ein Signal – nicht mehr, aber auch nicht weniger. Die anstehenden Prüfungen durch die Rechtsaufsicht oder gegebenenfalls Gerichte werden zeigen, ob der Beschluss Bestand hat oder angepasst werden muss.
🗨️ Kommentar der Redaktion Kommunalpolitik sollte sich nicht in Bundeszuständigkeiten verheddern. Symbolische Beschlüsse ersetzen keine handfeste Stärkung von Landes- und Bündnisverteidigung. Wer Nachwuchswerbung auf öffentlichen Flächen pauschal ausschließt, setzt das falsche Signal und führt Debatten fern der Sachebene. Stabilität entsteht durch klare Kompetenzordnung und durch Konzentration auf Fähigkeiten statt Schaufensterpolitik. Nüchterner Pragmatismus ist gefragt, nicht symbolische Moraldebatten.